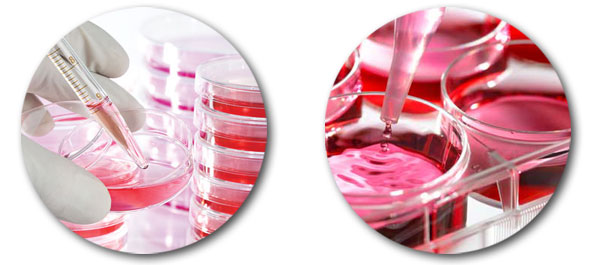

Clinical ResearchFrontier Mediville
Clinical ResearchFrontier Mediville
Advantage Mediville

Location: INDIA
The Republic of India is the most populous democracy in the world. It is the seventh largest country by area, and home to the second largest population in the world.
A Nation rich in culture and heritage, India’s promising outlook sets a strong foundation for an exciting future is currently the second fastest growing economy in the world. Total exports from the country grew at a pace of 22 percent over the last four years.
The Indian government’s continued commitment to improve the country’s infrastructure has served as the platform for the presence of a board spectrum of diverse industries. The country also offers a highly skilled workforce that is well educated yet relatively inexpensive to employ, positioning the nation as the preferred destination for investors seeking a strategic advantage.
Location Advantage
- The second fastest growing major economy in the world
- Situated along NH-5, Connecting Chennai to Kolkata.
- 70 kms from Chennai Airport
- 55 kms from Ennore Port
- 10 kms from Sri City – 10,000 acre multi-product SEZ
- 5 Kms from 1000 acre Mahindra World City (new)
- 1,000 acre SIPCOT industrial estate - housing Indian Petroleum majors & Automotive ancillaries
- Proximity to over 800 Pharmaceutical units

Skill Advantage
Our experts have more than 15 years experience in various CROs, Quality Testing laboratories and Pharma industries is research and testing services. Frontier Mediville aspires to provide its testing services promptly with comprehensive quality assurance programme to garner utmost Customer satisfaction in terms of reliability, reproducibility and quality of data.
Facility Advantage
Mediville hosts one of the most modern testing facility with multitude of research & testing equipments under one “sterile” and “secure” roof. Some of the key instruments available for ready use by “researchers” include…

- HPLC
- FPLC ( Fast Performance Liquid Chromatography )
- Cooling Centrifuge
- Gas Chromatography
- Universal Testing Machine
- Real Time PCR & Gradient PCR machines
- Double Beam UV-Visible Spectrophotometer
- Cooling Gas Incubator
- Stability chamber
- Inflation Tester
- Ultra & Deep Freezer
- Blood Bag tester
- Specimen cutter for latex products
- Water Leakage Tester
- Refrigerated Centrifuge
- CO2 Incubator
- Inverted Microscope & Inverted florescent Microscope
- BOD Incubator
- ELISA READER
- Gel documentation system
- Electro spinning Machine
SEZ Advantage (Special Economic Zone)
All incentives and concessions applicable to Special Economic Zones will be available to investors, including Income Tax Concessions for up to 15 years and exemption from Customs / Excise taxes.
- No license required for import made under SEZ units.
- Duty free import or domestic procurement of goods for setting up of the SEZ units.
- 15 year corporate tax holiday on export profit – 100% for initial 5 years, 50% for the next 5 years and up to 50% for the balance 5 years equivalent to profits ploughed back for investment.
- Allowed to carry forward losses.
- Goods imported/procured locally are duty free and could be utilized over the approval period of 5 years.
- Exemption from customs duty on import of capital goods, raw materials, consumables, spares, etc.
- Exemption from Central Excise duty on the procurement of capital goods, raw materials, and consumable spares, etc. from the domestic market.
- Exemption from payment of Central Sales Tax on the sale or purchase of goods, provided that, the goods are meant for undertaking authorized operations.
- Exemption from payment of Service Tax.
- The sale of goods or merchandise that is manufactured outside the SEZ (i.e, in DTA) and which is purchased by the Unit (situated in the SEZ) is eligible for deduction and such sale would be deemed to be exports.
- The SEZ unit is permitted to realize and repatriate to India the full export value of goods or software within a period of twelve months from the date of export.
- “Write-off” of unrealized export bills is permitted up to an annual limit of 5% of their average annual realization.
- No routine examination by Customs officials of export and import cargo.
- Setting up Off-shore Banking Units (OBU) allowed in SEZs.
- OBU's allowed 100% income tax exemption on profit earned for three years and 50 % for next two years.
- Exemption from requirement of domicile in India for 12 months prior to appointment as Director.
- Since SEZ units are considered as ‘public utility services’, no strikes would be allowed in such companies without giving the employer 6 weeks prior notice in addition to the other conditions mentioned in the Industrial Disputes Act, 1947.
- The Government has exempted SEZ Units from the payment of stamp duty and registration fees on the lease/license of plots.
- External Commercial Borrowings up to $ 500 million a year allowed without any maturity restrictions.
- Enhanced limit of Rs. 2.40 crores per annum allowed for managerial remuneration.








 +91 44-27940017
+91 44-27940017